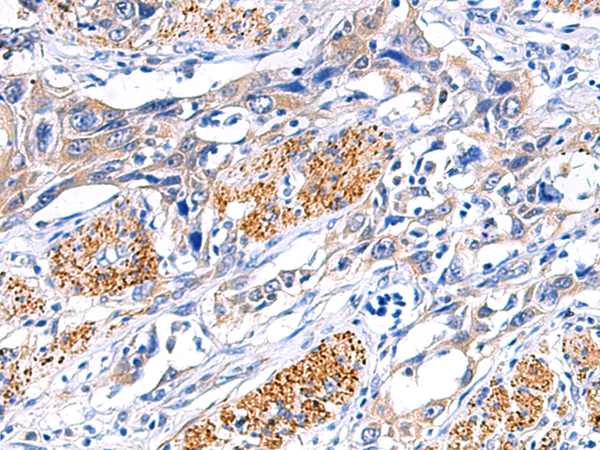

-
分类: 科研抗体货号: P06399别名: DRG11; PRRXL1应用: IHC反应种属: Human, Mouse, Rat
-
分类: 科研抗体货号: P06397别名: VF2; DPL1; DPPX; MRD33应用: IHC反应种属: Human, Mouse, Rat
-
分类: 科研抗体货号: P06442别名: IL-34; C16orf77应用: WB,IHC反应种属: Human
-
分类: 科研抗体货号: P06391别名: RBMS4应用: IHC反应种属: Human, Mouse
-
分类: 科研抗体货号: P06470别名: EVI1; MDS1; KMT8E; PRDM3; RUSAT2; MDS1-EVI1; AML1-EVI-1应用: WB,IHC反应种属: Human, Mouse
-
分类: 科研抗体货号: P06441别名: PC; APC; PROC1; THPH3; THPH4应用: WB,IHC反应种属: Human
-
分类: 科研抗体货号: P06390别名: JDD1; SB73; HDJC9应用: WB,IHC反应种属: Human
-
分类: 科研抗体货号: P06466别名: RBM35B应用: WB,IHC反应种属: Human, Mouse, Rat
-
分类: 科研抗体货号: P06439别名: EVPK应用: IHC反应种属: Human, Mouse
-
分类: 科研抗体货号: P06388别名:应用: IHC反应种属: Human, Mouse

鄂公网安备42018502007531号
鄂公网安备42018502007531号

